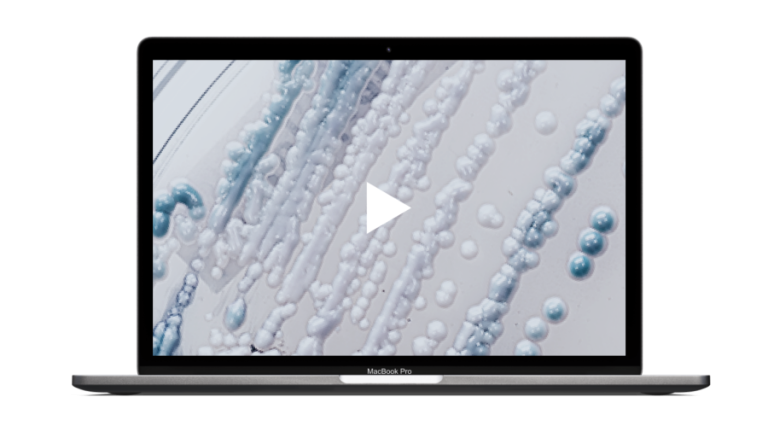
decoderm tri thumbnail v2

Entzündliche Mykosen – Diagnose, Behandlung, Fallbeispiele

Dermatologische Fortbildung
Die Reihe „Dermatologische Fortbildung“ unterstützt Sie mit Tipps und Fällen aus der Praxis bei Ihrer Arbeit in der täglichen Praxis.

Fortbildungsreihe: Fälle aus der Praxis
Dermatologinnen und Dermatologen stellen interessante Fallbeispiele aus ihrem Praxis-Alltag ausführlich vor und geben Hintergrundinformationen sowie nützliche Praxistipps.

Patientenmaterial
Hier steht Ihnen eine Reihe von Materialien zum Download bereit, die zur Aufklärung und Unterstützung betroffener Patientinnen und Patienten bei verschiedenen dermatologischen Erkrankungen dienen.

hautnah lernen
In der Reihe “hautnah lernen“ stellen Ihnen Kolleginnen und Kollegen interessante dermatologische Fälle in einem kurzweiligen ca. fünfminütigen Video vor.

Derma-Showroom

RG-Online-Fortbildung: Bericht
Die Veranstaltungen, gesponsert durch die Almirall Hermal GmbH, bieten qualitativ hochwertige Fachvorträge von Spezialistinnen und Spezialisten zu aktuellen Themen der Dermatologie.

Medical Tribune Magazin
Hier finden Sie Magazinausgaben von Medical Tribune, in denen es um entzündliche Hauterkrankungen wie Ekzeme, atopische Dermatitis oder Ringelflechte geht – kompakt aufbereitet und praxisnah für den dermatologischen Alltag.

Miconazol – breite antiinfektive Wirkung
Miconazol ist ein Hemmstoff der Ergosterolsynthese und als Breitband-Antimykotikum (ATC-Code D01AC02) bekannt. Untersuchungen zeigen aber auch weitere konzentrationsabhängige Wirkmechanismen.

Medikamenten-Porträt
Gezielt gegen Hautinfektionen
Hautinfektionen können unangenehm und langwierig sein. Eine gezielte Behandlung ist entscheidend. Sehen Sie, welche Wirkstoffe dabei helfen können und warum eine Kombinationstherapie sinnvoll ist.
Quellen
- Bath-Hextall FJ, Birnie AJ, Ravenscroft JC, et al. Interventions to reduce Staphylococcus aureus in the management of atopic eczema: an updated Cochrane review. Br J Dermatol. 2011;164:12–26.
- Breuer K, Kapp A, Werfel T. Bacterial infections and atopic dermatitis. Allergy. 2001;56(11):1034–41.
- Kolb-Mäurer, A. Das kutane Mikrobiom: Ausblick für neue Therapieansätze beim atopischen Ekzem. Aktuelle Dermatol. 2017;43(12):518–23.
Bildnachweise
Visual Content Hub Almirall/© [M] Putita / shutterstock.com; Almirall Hermal GmbH, Teaserbild Mykosen nach Tierkontakt/© goodluz / | Abb.: Sommer im Freibad Abbildungen; Bildquelle: ©Lincoln Beddoe; istock.com | Bildrecht „infizierter Unterarm“ – Bildquelle Dr. med. V. Czaika, Berlin | Miconazol – Bildquelle: James Gathany, Public domain, via CDC, https://phil.cdc.gov/Details.aspx?pid=16813 | Bildrecht „1302607167“ – Bildquelle: www.Istock.com/ Lyndon Stratford – Stock-Fotografie-ID:1302607167 | Bildrecht “2195168064” – Bildquelle: www.Istock.com/Cata Arango


